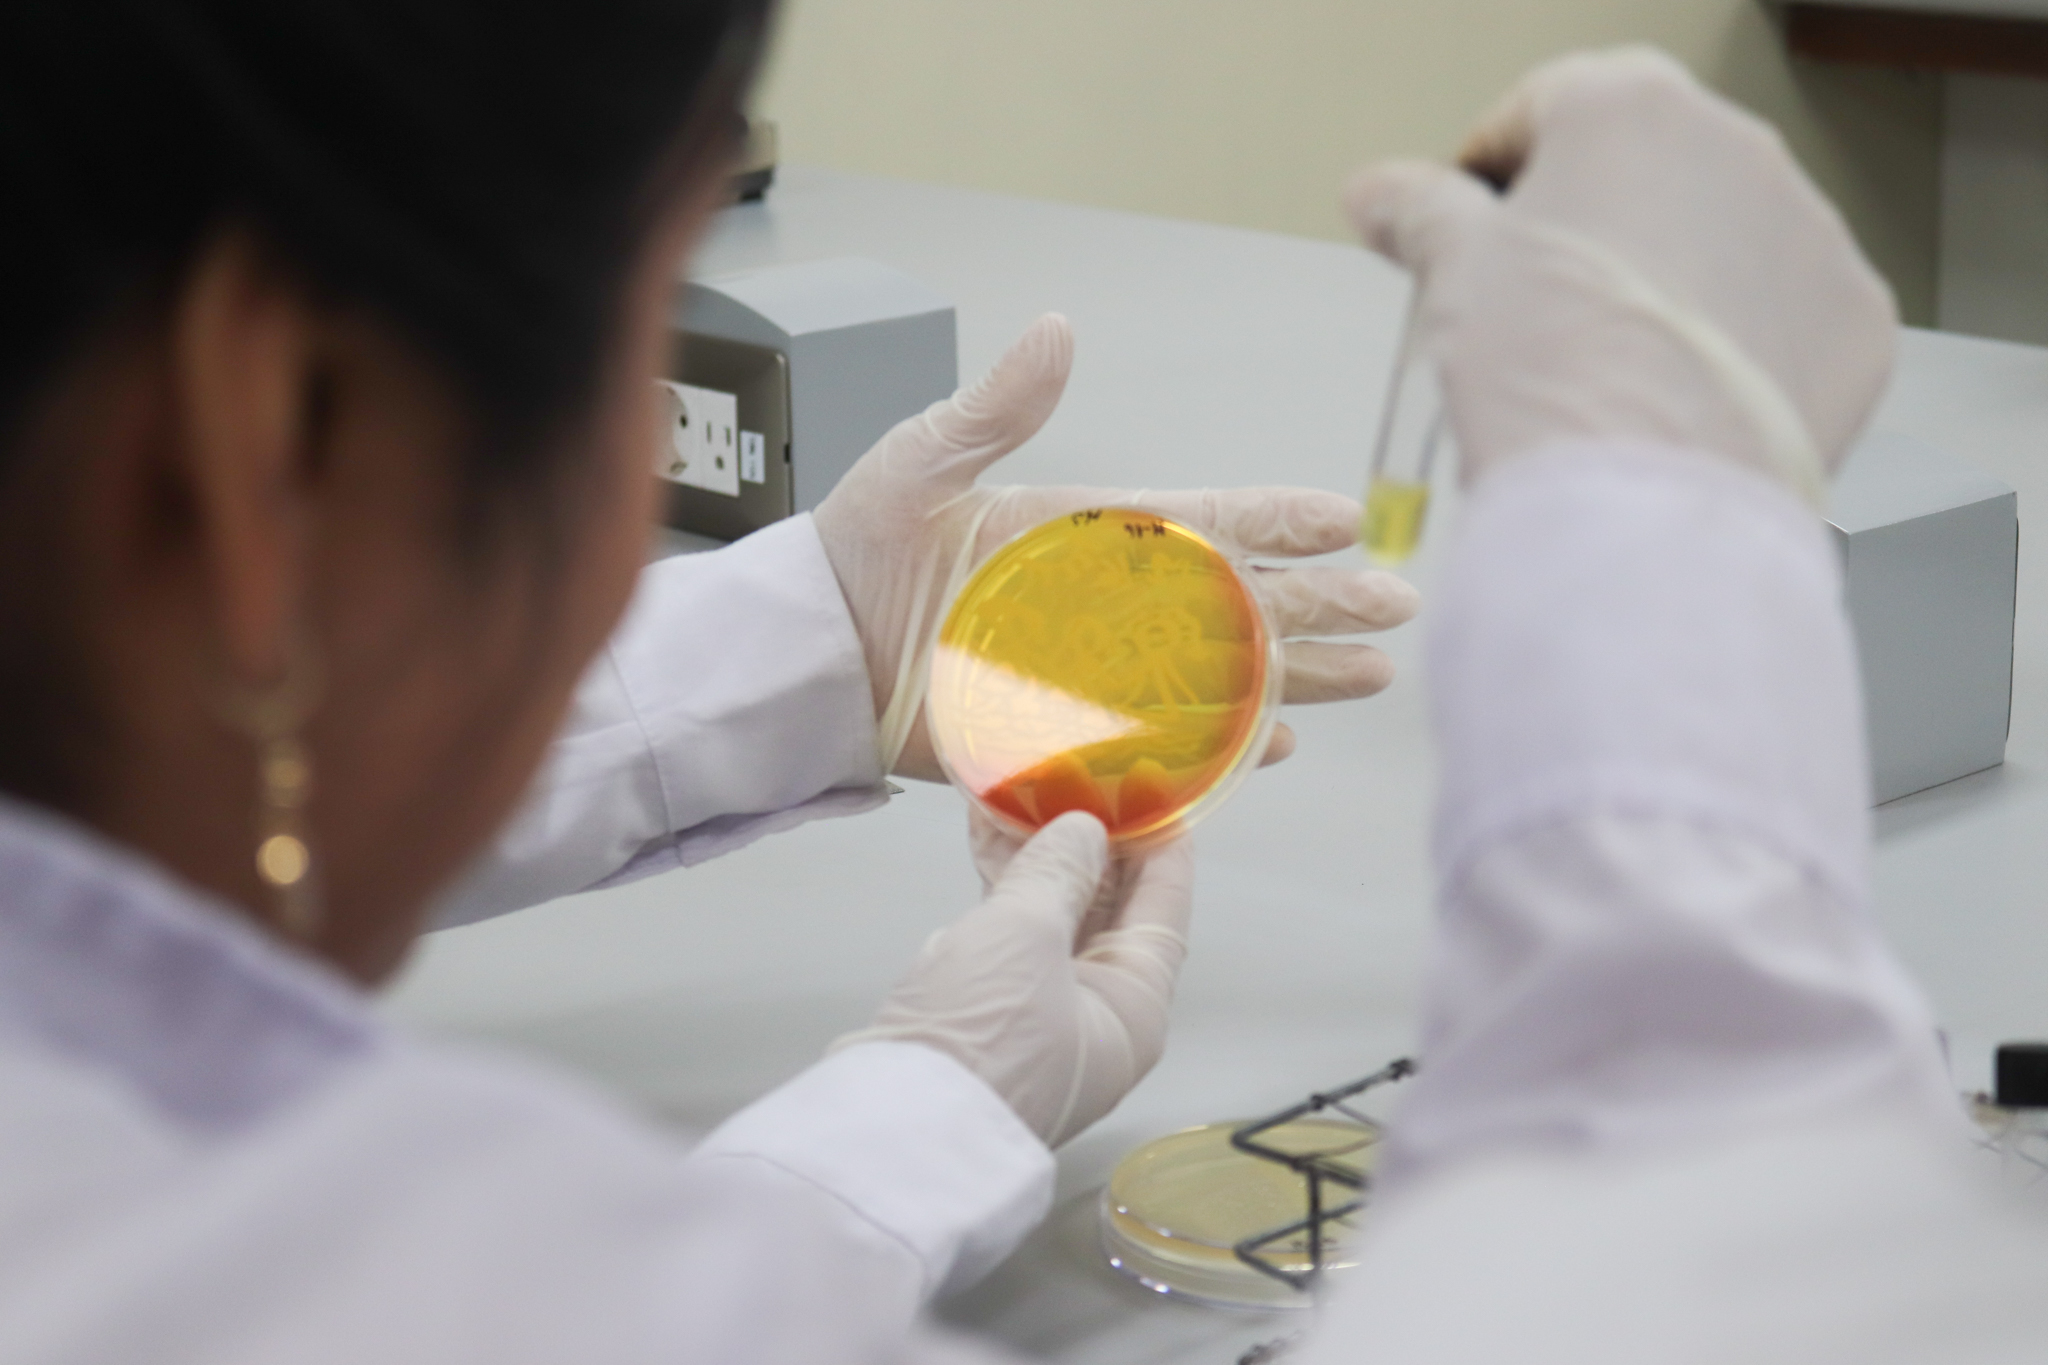

Laboratorio de Bacteriología desarrolló curso práctico “Técnicas Básicas en Microbiología”

Del 23 al 27 de febrero de 2026, el Laboratorio de Bacteriología llevó a cabo el curso “Técnicas Básicas en Microbiología”, una experiencia formativa orientada a fortalecer las competencias prácticas en el manejo de herramientas fundamentales del laboratorio microbiológico.
Durante cinco jornadas intensivas, profesionales y estudiantes provenientes de diversas instituciones educativas y del sector salud de Lima y de distintas regiones del país participaron en esta capacitación, cuyo enfoque eminentemente práctico permitió a cada asistente desarrollar habilidades directamente en el laboratorio.
El curso contó con el acompañamiento cercano del equipo docente, lo que favoreció un proceso de aprendizaje casi individualizado y facilitó la comprensión de los fundamentos microbiológicos, así como su adecuada aplicación en el trabajo experimental.

Asimismo, la activa participación de los asistentes, el intercambio de experiencias entre profesionales de distintas disciplinas y el compromiso del equipo docente contribuyeron al desarrollo exitoso de esta actividad académica, cumpliendo ampliamente las expectativas de los participantes.
Esta iniciativa reafirma la importancia de la formación práctica en microbiología como un componente clave para el fortalecimiento de capacidades en el ámbito académico y profesional.



